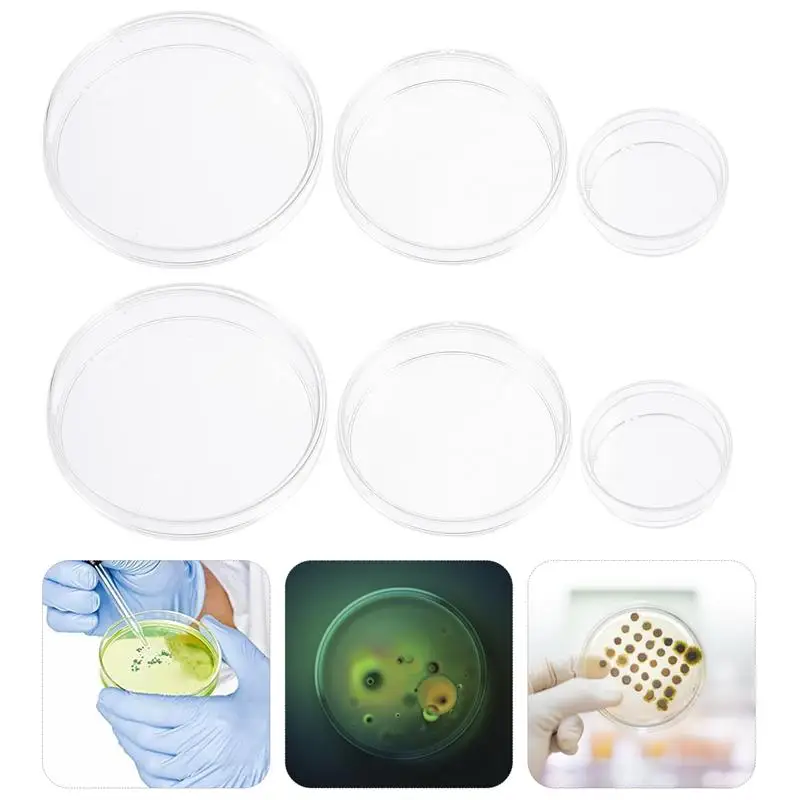

30 шт прозрачные чашки Петри с крышками Пластик Стерильная чаша химической
Сохраните в закладки:






История цены
*История изменения цены! Указанная стоимость возможно, уже изменилось. Проверить текущую цену - >
| Месяц | Минимальная цена | Макс. стоимость | Цена |
|---|---|---|---|
| Sep-15-2025 | 0.66 руб. | 0.87 руб. | 0 руб. |
| Aug-15-2025 | 0.87 руб. | 0.77 руб. | 0 руб. |
| Jul-15-2025 | 0.68 руб. | 0.80 руб. | 0 руб. |
| Jun-15-2025 | 0.1 руб. | 0.50 руб. | 0 руб. |
| May-15-2025 | 0.10 руб. | 0.70 руб. | 0 руб. |
| Apr-15-2025 | 0.65 руб. | 0.8 руб. | 0 руб. |
| Mar-15-2025 | 0.98 руб. | 0.48 руб. | 0 руб. |
| Feb-15-2025 | 0.65 руб. | 0.80 руб. | 0 руб. |
| Jan-15-2025 | 0.28 руб. | 0.14 руб. | 0 руб. |
Новые товары
Новая оригинальная серия Labubu V3 The Monsters Big Into Energy виниловая кукла с лицом модная
Велосипед электрический для взрослых с задним сиденьем и передней корзиной 1000 Вт
Микросхема ANBERNIC RG353V RG353VS 512GB TF карта предварительного загрузки игр PSP DC SS PS1 NDS
ИНСТРУМЕННАЯ ДОСТАВКА НА 4-канальную DJ-систему Pioneer DJ OPUS-QUAD
Кобура в средневековом стиле для пистолета
Устройство чтения карт TF Huawei HuaWei P40mate20/30/40Pro
Автомобильный переключатель регулировки громкости рулевого колеса для VW Jetta 5 MK5 6
Реле RY610024 24V 8A 5PIN
Характеристики
30 шт прозрачные чашки Петри с крышками Пластик Стерильная чаша химической
Описание товара
Вы ищете профессиональную, но доступную чашку Петри? Вы ищете прочный, надежный инструмент, который может выполнять несколько работ одновременно? Если да, не ищите дальше! Наш профессиональный набор Петри вам понадобится. Это один из лучших вариантов для вас.
Характеристики
-Цвет:Прозрачный.
-Материал: пластик.
-Размер: около6.70X6.70X1.80 см/X x дюйма.
-Изготовлен из высококачественного пластика с процессом стерилизации.
-Продукт абсолютно чистый и однородный по толщине. Количественный анализ более точный, отличный выбор для использования чашек Петри.
-Благодаря дизайну крышки его удобно использовать и транспортировать.
-Конструкция зубцов на боковой стороне делает блюдо легким в удержании и снижает загрязнение.
-Подходит для лабораторий, биологических и научных исследований и т. д.
Упаковочный лист
Чашки Петри 10x35 мм
Чашки Петри 10x60 мм
Чашки Петри 10x70 мм










Трекер стоимости
Отзывы покупателей
Новые отзывы о товарах
Заказывали тут, для фотосессии с новорожденной дочей. Удобно одевать, максимально простое, и в то же время очень красивое! Юбочка нам... Читать отзыв полностью...
Платье очень деликатное и умело подчеркивает все достоинства фигуры, особенно талию. Отлично подойдет как в офис, так и на прогулку... Читать отзыв полностью...
Очень долго искала такое платье, хотелось что-то простое но интересное, и вот наткнулась на него, заказала, спасибо за быструю доставку.... Читать отзыв полностью...
Что может быть лучше подарка для девочек, как ни кукольный домик? Это же настоящая мечта! Притом в игру затягивает не... Читать отзыв полностью...
Решила обновить свои наволочки для подушек. Мне понравились именно эти с рождественскими рисунками персикового цвета, что смотрятся прикольно и... Читать отзыв полностью...
Всё идеально !Теперь у меня есть новые замечательные часы !))Только сегодня забрала их..очень эффектные и красиво смотрятся на руке ))вживую... Читать отзыв полностью...

Понравилась рубашка и решил заказать. Пришла доставка за четыре месяца после оплаты товара, конечно, долго. По качеству нормальная вещь, а... Читать отзыв полностью...